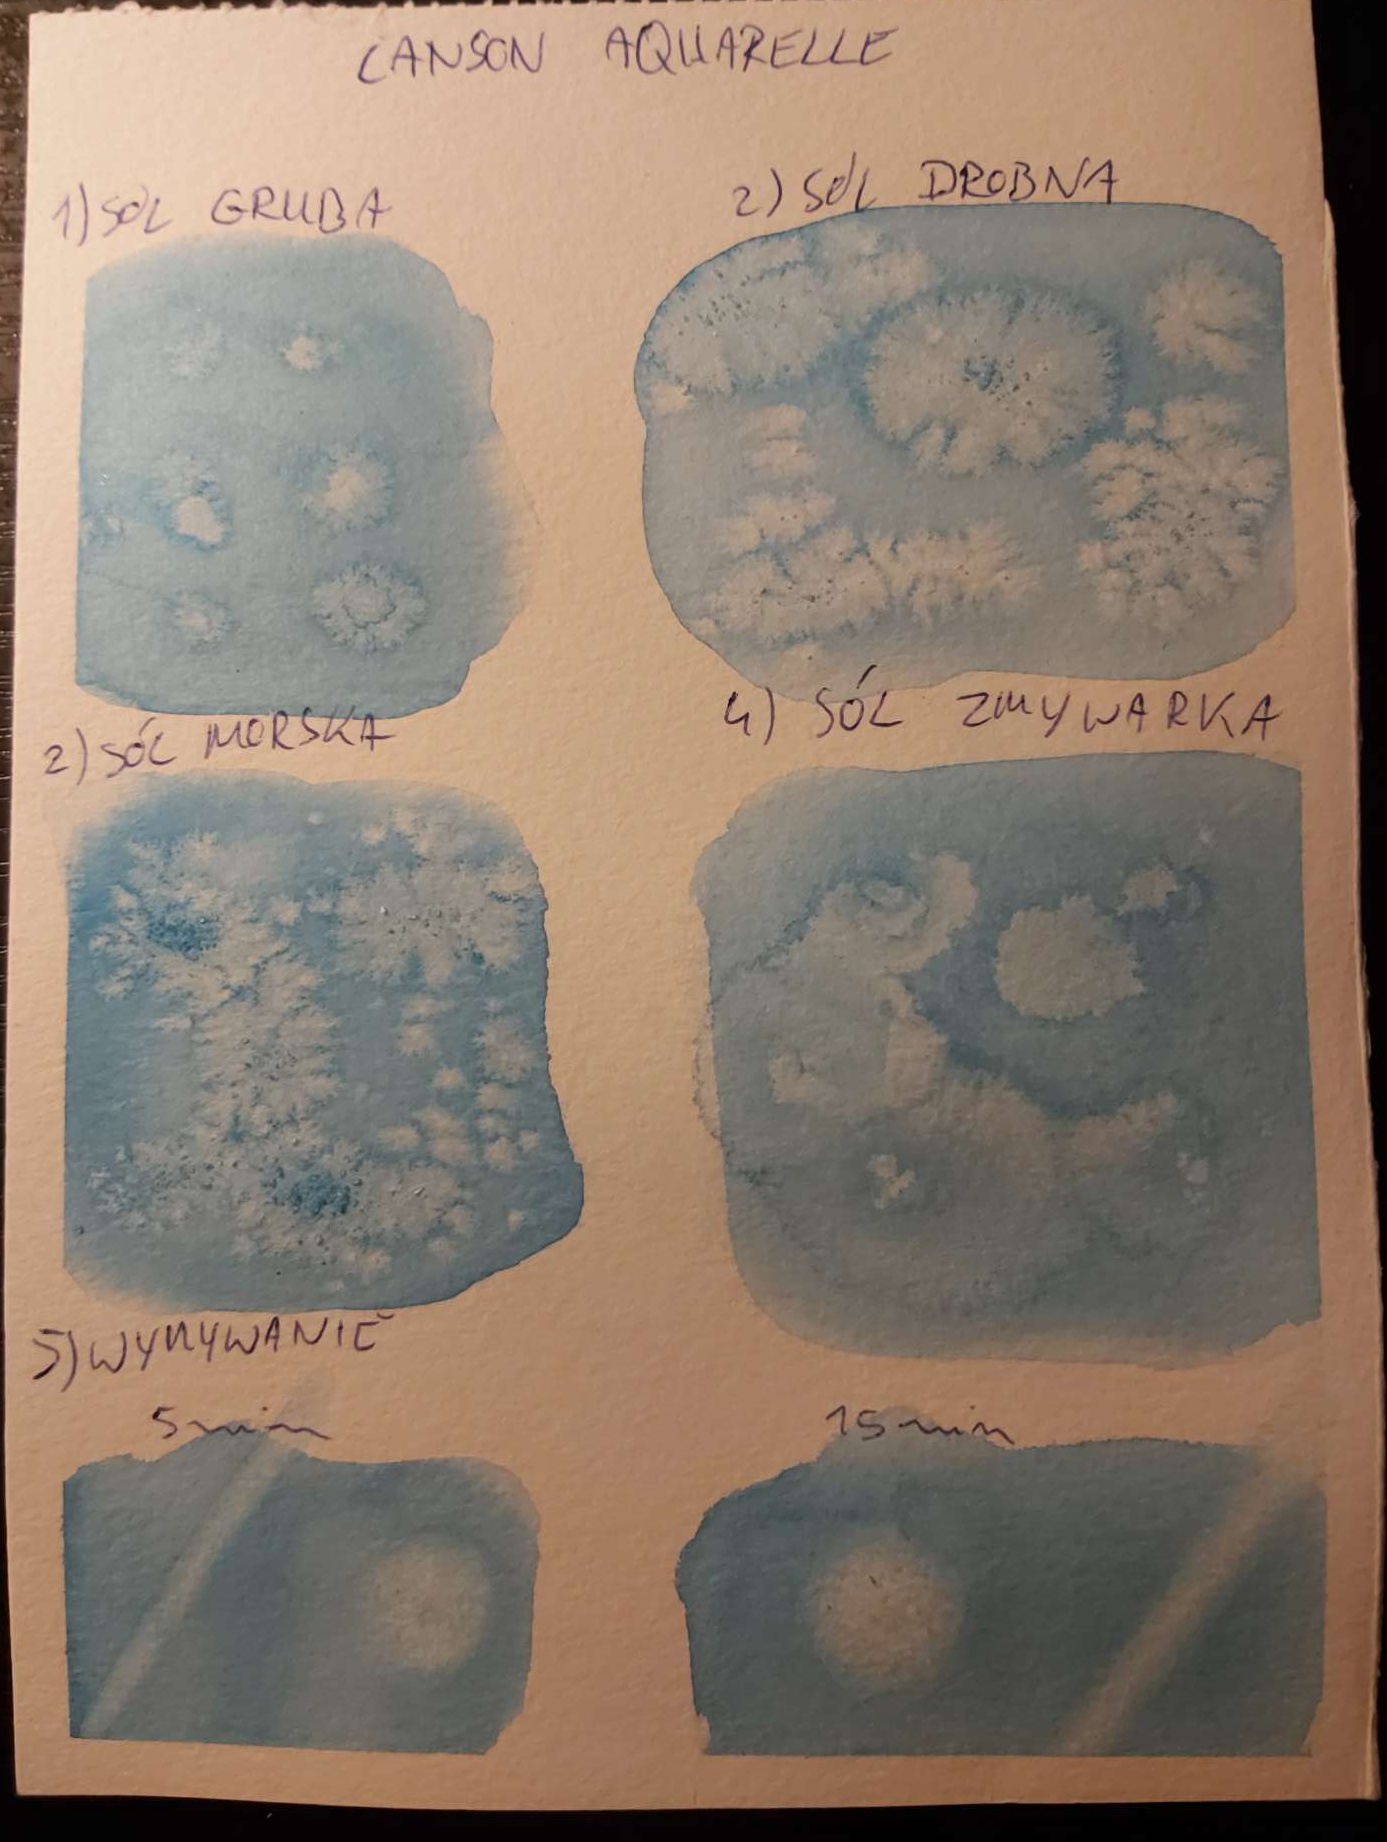

UWAGA !!!!!
TEKST POCHODZI Z 2020 ROKU, KIEDY PRACOWAŁAM GŁOWNIE NA TANICH PAPIERACH.
WRZUCAM GO ARCHIWALNIE DLA OSÓB KTÓRE DOPIERO ZACZYNAJĄ I CHCĄ JAK NAJTANIEJ- treść zawarta poniżej jest dla mnie nadal aktualna.
Dzisiaj post "branżowy", czyli TEST 4 papierów do akwareli (uwzględniono format A4):
1.Artist Aquarelle Paper Grain Fin 300g (cena ok 8zł w sklepie Action , 20zł na Allegro- 20 kartek)
2.Pallazo Herbaciana Róża o strukturze płótna 200g (cena od 12,5zł- 20 kartek, ma go sklep plastyczny Matejko)
3.Leniar 300g 30% bawełny (cena ok 13zł za 10 kartek, jest w PaperConcept)
4.Canson XL Aquarelle 300g (cena ok 35zł za 30 kartek, jest w PaperConcept)
Na papierze z Action pracowałam do tej pory regularnie (rok 2020) - opinie o nim bywają skrajne i wiele osób uważa, że nie nadaje się on do niczego poza wyrzuceniem do kosza. Czy to słuszna opinia?
Polemizowałabym.
Test wykonany był dla każdego papieru w ten sam sposób i z zachowaniem podobnych odstępów czasowych.
1. Kartka klejona taśmą do płyty.
2. Użyte farby: Białe Noce 519 Azure Blue, pędzle syntetyczne Crealando okrągłe
3. Po zmoczeniu kartki wodą, nakładana była mokra farba (technika mokre w mokre). Starałam się dawać ją w miarę równomiernie- ale papiery robiły swoje i są różnice: zarówno w intensywności jak i gładkości.
4. Na farbę sypałam sól: gruboziarnistą, drobnoziarnistą, drobnoziarnistą morską, sól do zmywarki firmy Kraft.
5. Na czystej farbie przesuszonej 5 lub 15 minut- wykonywałam test polegający na próbie wymycia nałożonej farby pędzelkiem.
Efekty:
1. Falowanie papieru
Tutaj nie ma zlituj, papier z Action poddaje się najłatwiej mimo 300g. Uważam to za wielką jego wadę- w akcie desperacji będę próbowała co się stanie jeśli potraktuję pracę żelazkiem...
Następny w kolejności jest Pallazo- faluje mniej, ale faluje. Canson Aquarelle i Leniar preznetują się pod tym względem najlepiej- choć nie są całkowicie płaskie po wyschnięciu.
2. Strzępienie się i uszkadzanie papieru
Action znów w czołówce- warstwy da się nakładać, wychodzą ładnie, ale już przy ostrzejszym wymywaniu czy próbie szorowania pędzlem po mokrej kartce trzeba uważać i to mocno. Robią się na nim kuleczki i "farfocle", choć nad dziurą trzeba popracować bo nie wypada od razu.
Pallazo herbaciana róża także ma tendencje do uszkadzania się papieru- choć mniejszą (ale radzę uważać na taśmę i suszyć suszarką przed zdjęciem- taśma uszkodziła mi inny kawałek tego papieru).
Totalnie żadnego problemu nie miałam wymywając papier Leniar i Canson Aquarelle- ten ostatni bardzo miło zaskoczył mnie swoją niebywałą sprężystością.
3. Intensywność koloru
Mam wrażenie, że największą intensywność koloru daje papier z Action. Starałam się nakładać podobne odcienie farby- ale Leniar i Canson Xl wyszły jaśniejsze. Pallazo wyszedł nieco jaśniejszy od Actiona- ale nadal ciemniejszy niż dwa pozostałe papiery. Próby z innymi kolorami przeprowadzę malując już gotowe, pełne prace.
4. Efekty specjalne (od soli)
Tutaj papier z Action wymiótł konkurencję- na nim wychodzą najwyraźniejsze i najpiękniejsze efekty.
Szczególnie ładnie wychodzi na nim sól do zmywarki, która na pozostałych papierach wychodzi bardzo słabo. Każdy z rodzajów użytej soli na Action wyszedł najlepiej- każdy dał tez inny efekt.
Drugi po nim jest Pallazo, praktycznie dzieląc miejsce z Canson. Najsłabiej efekt wychodzi na papierze Leniar- tu każda sól daje praktycznie taki sam efekt. Mam wrażenie, że jest to w dużej mierze efekt faktury papieru- jest znacznie bardziej wyraźna niż w pozostałych papierach.
5. Wymywanie koloru
Kolor mniej lub bardziej wymywał się z każdego z papierów- po 5 i 15 minutach- czyli pozwalał na szybkie poprawki.
Poziom wymycia się koloru na każdym z papierów wyszedł podobnie- choć zdecydowanie najbardziej naturalny efekt bez ostrych krawędzi dawał papier Canson Aquarelle, a potem Leniar. W przypadku Pallazo i papieru z Action- granice wymywania były bardziej widoczne.
6. Cena
Najkorzystniej wychodzi Artis Aquarelle Paper- poniżej 40gr/kartka jeśli kupi się go w markecie Action- jest jednak najgorzej dostępny. 2 miejsce- Pallazo Róża Herbaciana- 65gr/kartka. 3 miejsce Canson XL Aquarelle- 1,17zł/kartka. Na końcu jest Leniar- 1,3zł/kartka.
Jeśli bym miała wybierać patrząc na stosunek ceny, jakości i dostępności- uderzałabym w Pallazo HR lub Cansona XL Aquarelle.
Ocena końcowa
Który papier jest najlepszy?
Nie wiem.
Nie ma jasnej odpowiedzi w tym temacie.
Każdy z nich jest inny i trudno oceniać go jako lepszy czy gorszy. Dużo tutaj zależy do tego, do czego chcemy go wykorzystać i czy mamy cierpliwość.
Jeśli chcemy bajerów z solą i innych cudów- polecam przemęczyć się z kulkowaniem papieru z Action. Gra jest warta świeczki. Efekty zachwycają. Trzeba jednak ostrożnie i nie nastawiać się na zbyt głębokie poprawki. Wymywanie do czysta to nie jest jego najmocniejsza strona, choć przy dozie cierpliwości da się z nim uzyskać zadowalający efekt.
Jeśli chcemy płynnego wymywania bez strachu o uszkodzenie papieru- polecan Cansona XL Aquarelle. Jest najbardziej sprężysty i najładniej na nim rozpływa się farba- bardzo regularnie i przyjemnie. Efekty z soli też są widoczne, choć nie są spektakularne. Nie trzeba do niego żelaznych nerwów i dyscypliny. Jest przyjazny dla użytkownika i nie zniechęca.
Jeśli trzeba kompromisu pomiędzy efektami, intensywnością koloru i wymywaniem- warto przetestować Pallazo herbaciana Róża. Jego atutem jest też niewątpliwie delikatna, ale widoczna struktura płótna. Daje to ładny efekt końcowy,a pędzel sunie miękko. Bez odrobiny uwagi przy szorowaniu pędzlem się jednak nie obejdzie. To najcieńszy z papierów i trzeba to mieć na względzie.
Najciekawszy efekt strukturalny da natomiast papier z Leniara- jego faktura jest mocno widoczna. Trzeba tylko uważać przy nakładaniu farby- nakłada się nierównomiernie i warto gładzić pędzlem jeśli chce się uzyskać w miarę jednolity kolor. Efekty są na nim najmniej widoczne- ale jeśli chodzi nam tylko o jeden podstawowy wzór plamy z soli- to Leniar także da radę. Wymyje się w ładny sposób i papier nam się nie uszkodzi tak łatwo. Ale tę szorstkość trzeba zobaczyć zanim się kupi zapas, bo można się zdziwić... Na pewno jest mniej uniwersalny niż pozostałe.
Tyle z dzisiejszych testów.
P.S Za pierwszym razem wynik papieru z Action tak mnie zaskoczył w porównaniu z Pallazo, że aż powtórzyłam test- stąd na jednym ze zdjęć są podwójne wyniki. Nie mogłam uwierzyć, ze marketowy papier może dać lepszy efekt wizualny niż firmowy ze sklepu dla plastyków 🙂